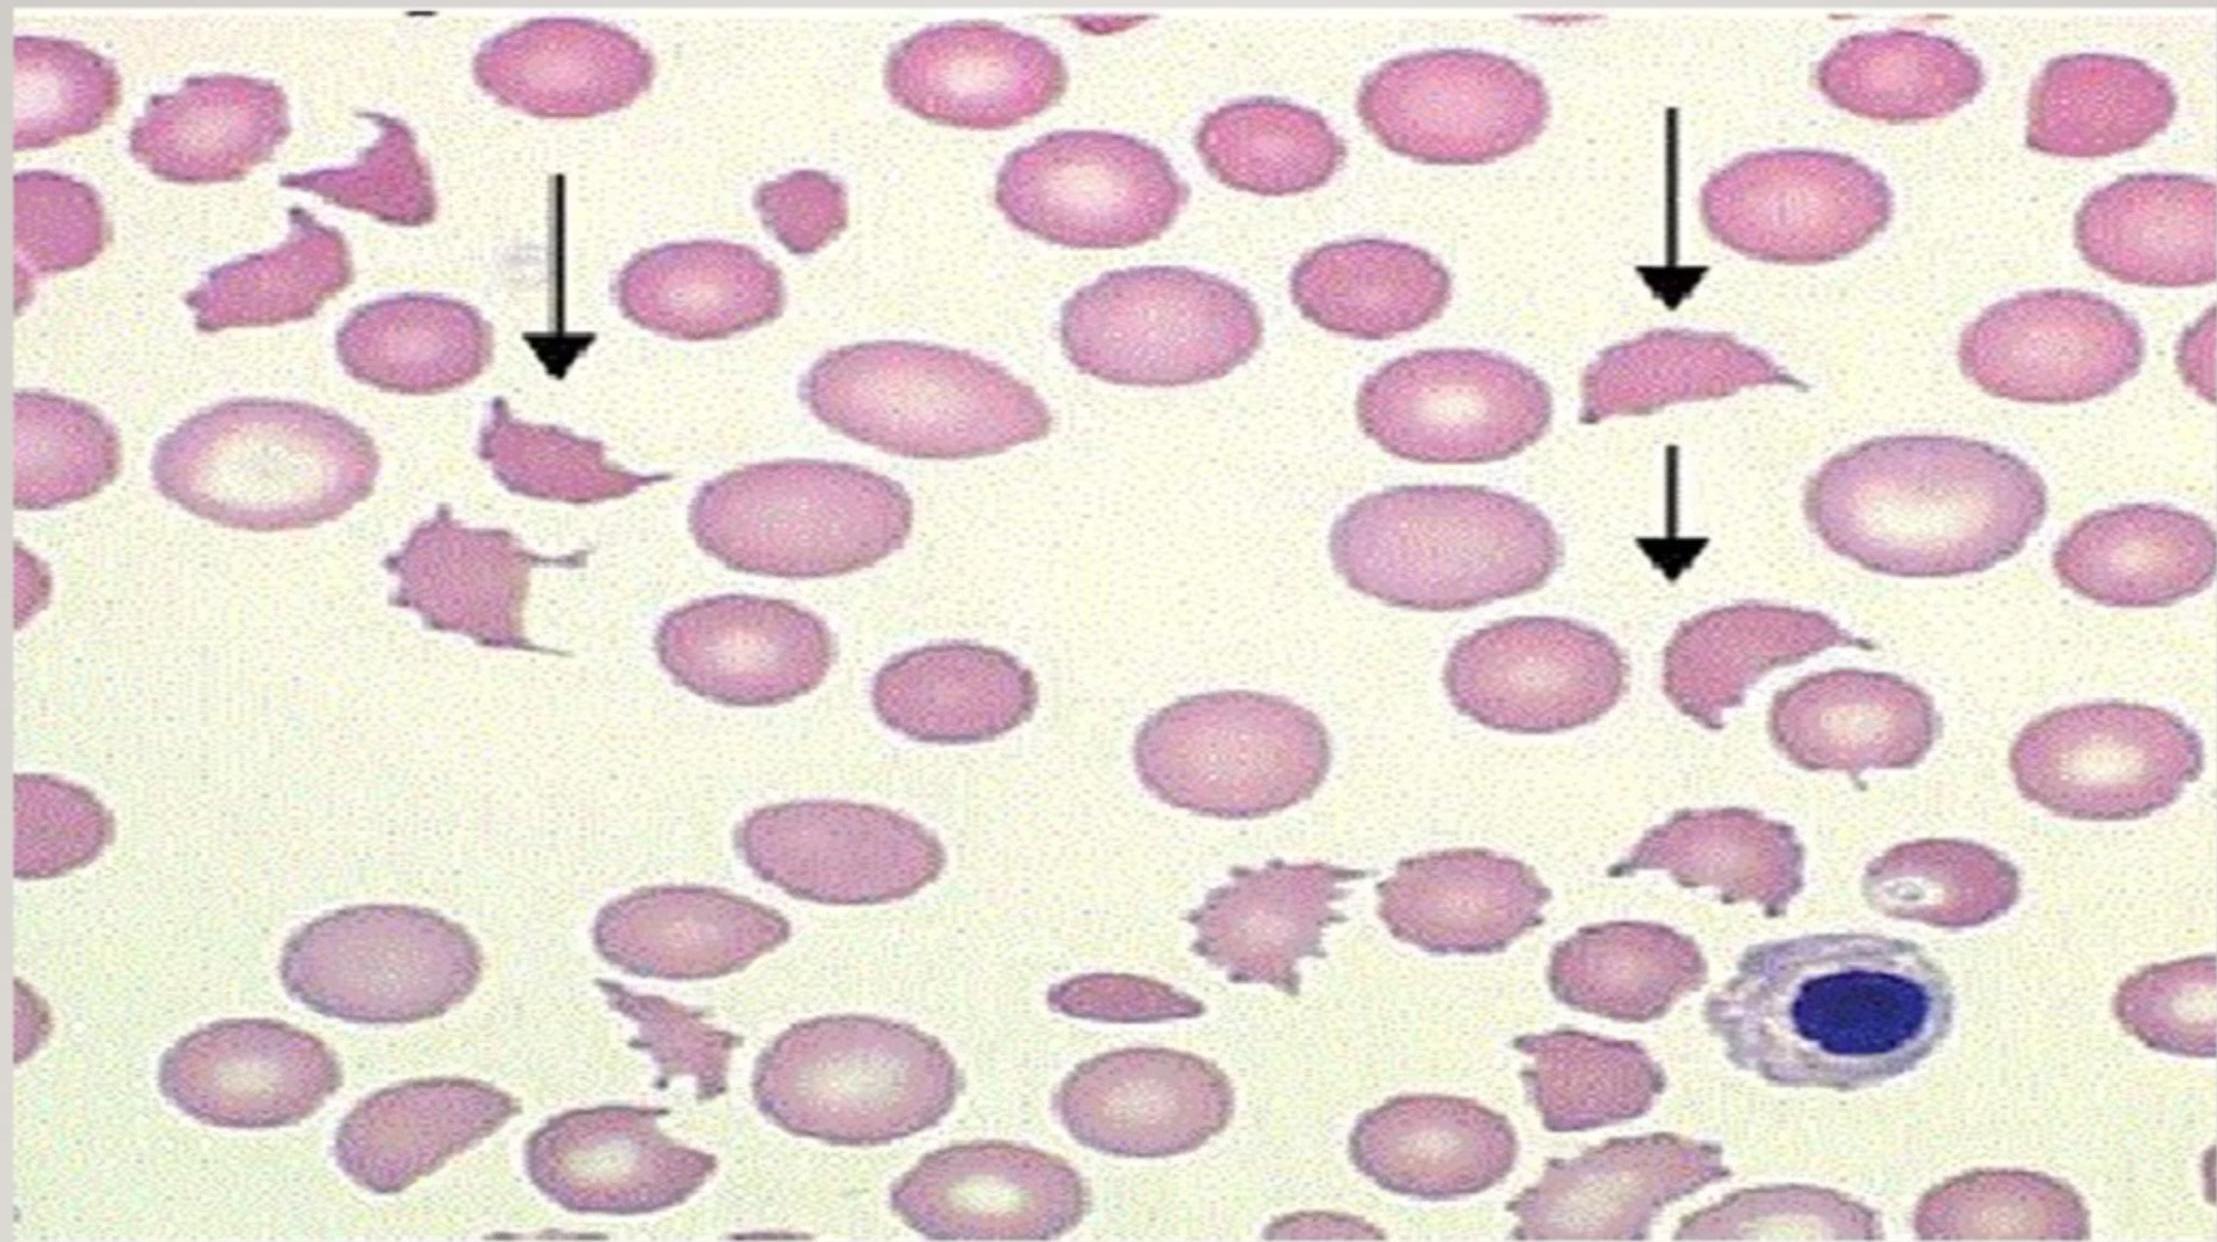
img-30.jpeg

The Classic Triad
- Acute Renal Failure: Progressive renal impairment.
- Microangiopathic Hemolytic Anemia: Fragmented erythrocytes (schistocytes) + hemolysis.
- Thrombocytopenia: Platelet consumption.



-1769064753749.webp)
Etiologies
- Typical HUS: E. coli O157:H7 (Shiga toxin). Undercooked beef, farm animals. Ages 2-5. Less commonly caused by Shigella infection
- Atypical HUS: Complement pathway genetic defects. Triggered by various infections. Poorer prognosis. Typically affects younger patients, Higher risk of recurrence and poorer prognosis
Pathophysiology
The pathophysiology of HUS can be visualized as a cascade of events:
- Prodrome – often starts with bloody diarrhea.
- Toxin invasion – bacterial toxins breach the gastrointestinal mucosa and preferentially attack kidney endothelial cells, prompting intravascular thrombogenesis.
- Coagulation activation – the coagulation cascade is switched on, yet clotting factor levels remain normal, a crucial clue that separates HUS from disseminated intravascular coagulation (DIC).
- Platelet and red‑cell damage – platelets are consumed to form microthrombi; red blood cells are sheared as they squeeze through the obstructed microvasculature, producing microangiopathic hemolytic anemia.
- Extra‑renal involvement – the same microvascular injury can also affect the brain, pancreas, and heart.
In short, bacterial toxins trigger endothelial injury in the kidneys, leading to microthrombi formation, platelet consumption, and red‑cell fragmentation, while preserving normal clotting factor levels and potentially impacting other organs.

-1769065026302.webp)
Clinical Presentation
HUS – Clinical Presentation & Typical Progression
-
Prodromal phase
- Often follows an acute gastro‑enteritis or pneumonia
- Fever, vomiting, abdominal pain
- Initial watery diarrhea
-
Progression phase
- Diarrhea turns bloody
- Dehydration sets in
- Early signs of renal involvement appear
-
Established disease
- Edema and petechiae (from thrombocytopenia)
- Hepatosplenomegaly
- Hypertension
- Pallor & lethargy due to anemia
In summary, HUS usually starts with gastrointestinal symptoms and then evolves into the classic triad of renal failure, hemolytic anemia, and thrombocytopenia.
 The clinical progression typically begins with gastrointestinal symptoms followed by manifestations of the classic triad: renal failure, hemolytic anemia, and thrombocytopenia.
The clinical progression typically begins with gastrointestinal symptoms followed by manifestations of the classic triad: renal failure, hemolytic anemia, and thrombocytopenia.
Diagnosis
Hemolytic Uremic Syndrome – Diagnostic Overview
-
Core triad:
Microangiopathic hemolytic anemia + thrombocytopenia + acute kidney injury -
Hematologic clues
- Peripheral smear: schistocytes, burr cells, or helmet cells
- Hemoglobin: usually 5–9 g/dL
- Leukocytosis can exceed 30,000 /µL — a marker of poorer renal outcome
- Thrombocytopenia appears in ≈ 90 % of cases
-
Renal indicators
- Elevated BUN & creatinine with oliguria or anuria
- Microscopic hematuria and proteinuria
-
Coagulation profile
- PT and PTT are typically normal – a key point that distinguishes HUS from DIC
Diagnosis hinges on recognizing the classic triad together with the laboratory pattern above; normal coagulation amid microangiopathic hemolysis is especially characteristic of HUS.
Microangiopathic Hemolytic Anemia in HUS – Peripheral Blood Smear Findings
Microangiopathic Hemolytic Anemia in HUS – Peripheral Blood Smear Findings
The smear shown is taken from a patient with microangiopathic hemolytic anemia secondary to HUS. The arrows point to schistocytes—fragmented red blood cells that arise when erythrocytes are forced through partially occluded micro‑vessels. These schistocytes are pathognomonic for the condition and form a cornerstone of the HUS diagnosis.
Additional morphological clues that may appear are:
- Helmet cells – another form of fragmented RBCs
- Spherocytes – rounded cells indicating membrane loss
- Polychromasia – a spectrum of bluish‑tinted reticulocytes reflecting the bone‑marrow response to ongoing hemolysis
Together, these findings provide a clear visual signature of microangiopathic hemolysis in HUS.
Management
Hemolytic Uremic Syndrome – treatment approach
Supportive care
- Meticulous fluid & electrolyte management
- Blood‑pressure control
- Early dialysis when indicated
- Nutritional support / anemia management
Antibiotic considerations
- Contraindicated if E. coli O157:H7 is suspected – antibiotics may trigger toxin release and aggravate the disease.
Atypical HUS
- Requires complement‑system blockade
- Eculizumab – an anti‑C5 antibody that blocks complement activation
- Dramatic improvement in outcomes with this targeted therapy.




Hemolytic Uremic Syndrome – Prognosis
Typical HUS
- Generally favorable when early supportive care (e.g., dialysis) is given.
- Long‑term follow‑up is essential because of the risk of:
- Persistent proteinuria
- Hypertension development
- Progressive chronic kidney disease
Atypical HUS
- Historically poor outlook: often no diarrheal prodrome, possible familial pattern, frequent relapses, and a high risk of hypertension, CKD, and mortality.
- Eculizumab has dramatically improved outcomes despite its high cost.
- Plasma exchange remains in use, especially for cerebral‑dominant atypical cases.